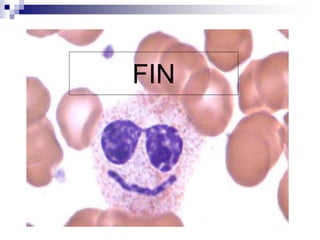
FIN

Este documento proporciona información sobre el hemograma manual. Define el hemograma como el estudio cualitativo y cuantitativo de los elementos corpusculares de la sangre. Explica los procedimientos para realizar recuentos de glóbulos blancos, rojos y plaquetas, hematocrito, dosaje de hemoglobina y fórmula leucocitaria. También cubre valores de referencia y etapas pre-analíticas como la toma de muestra.